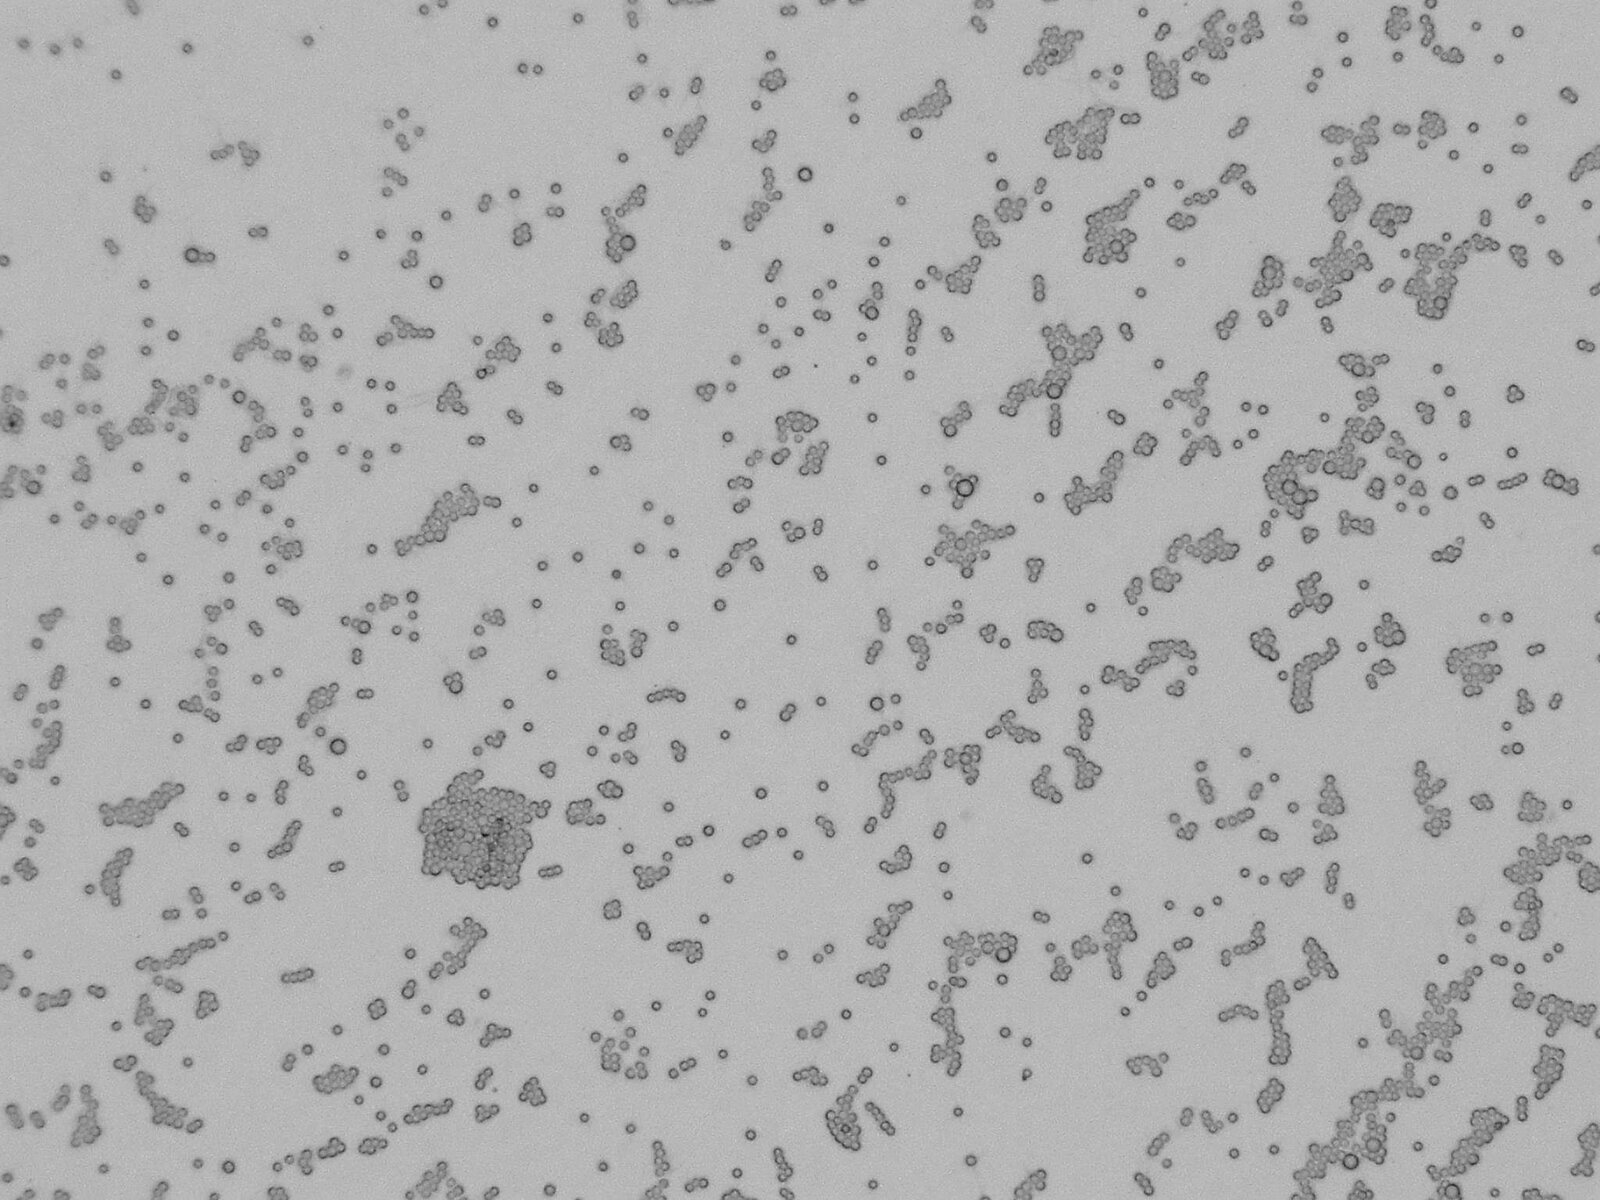
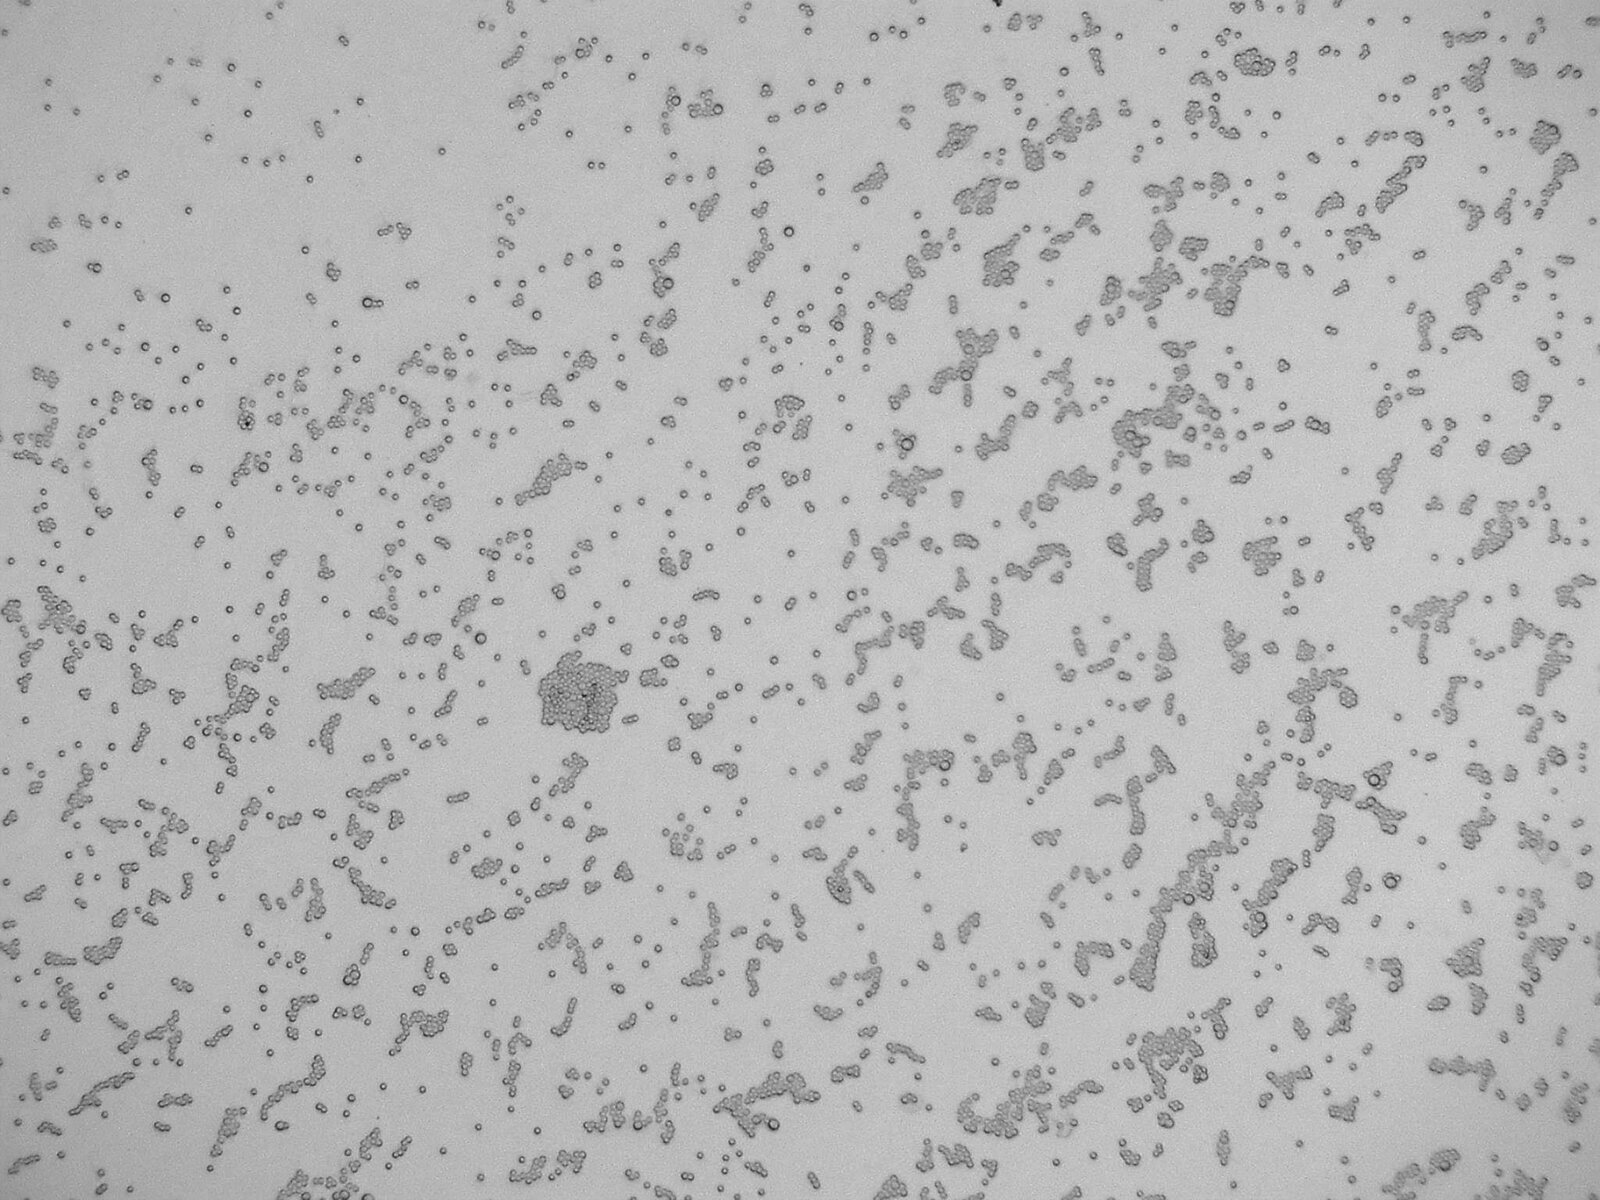
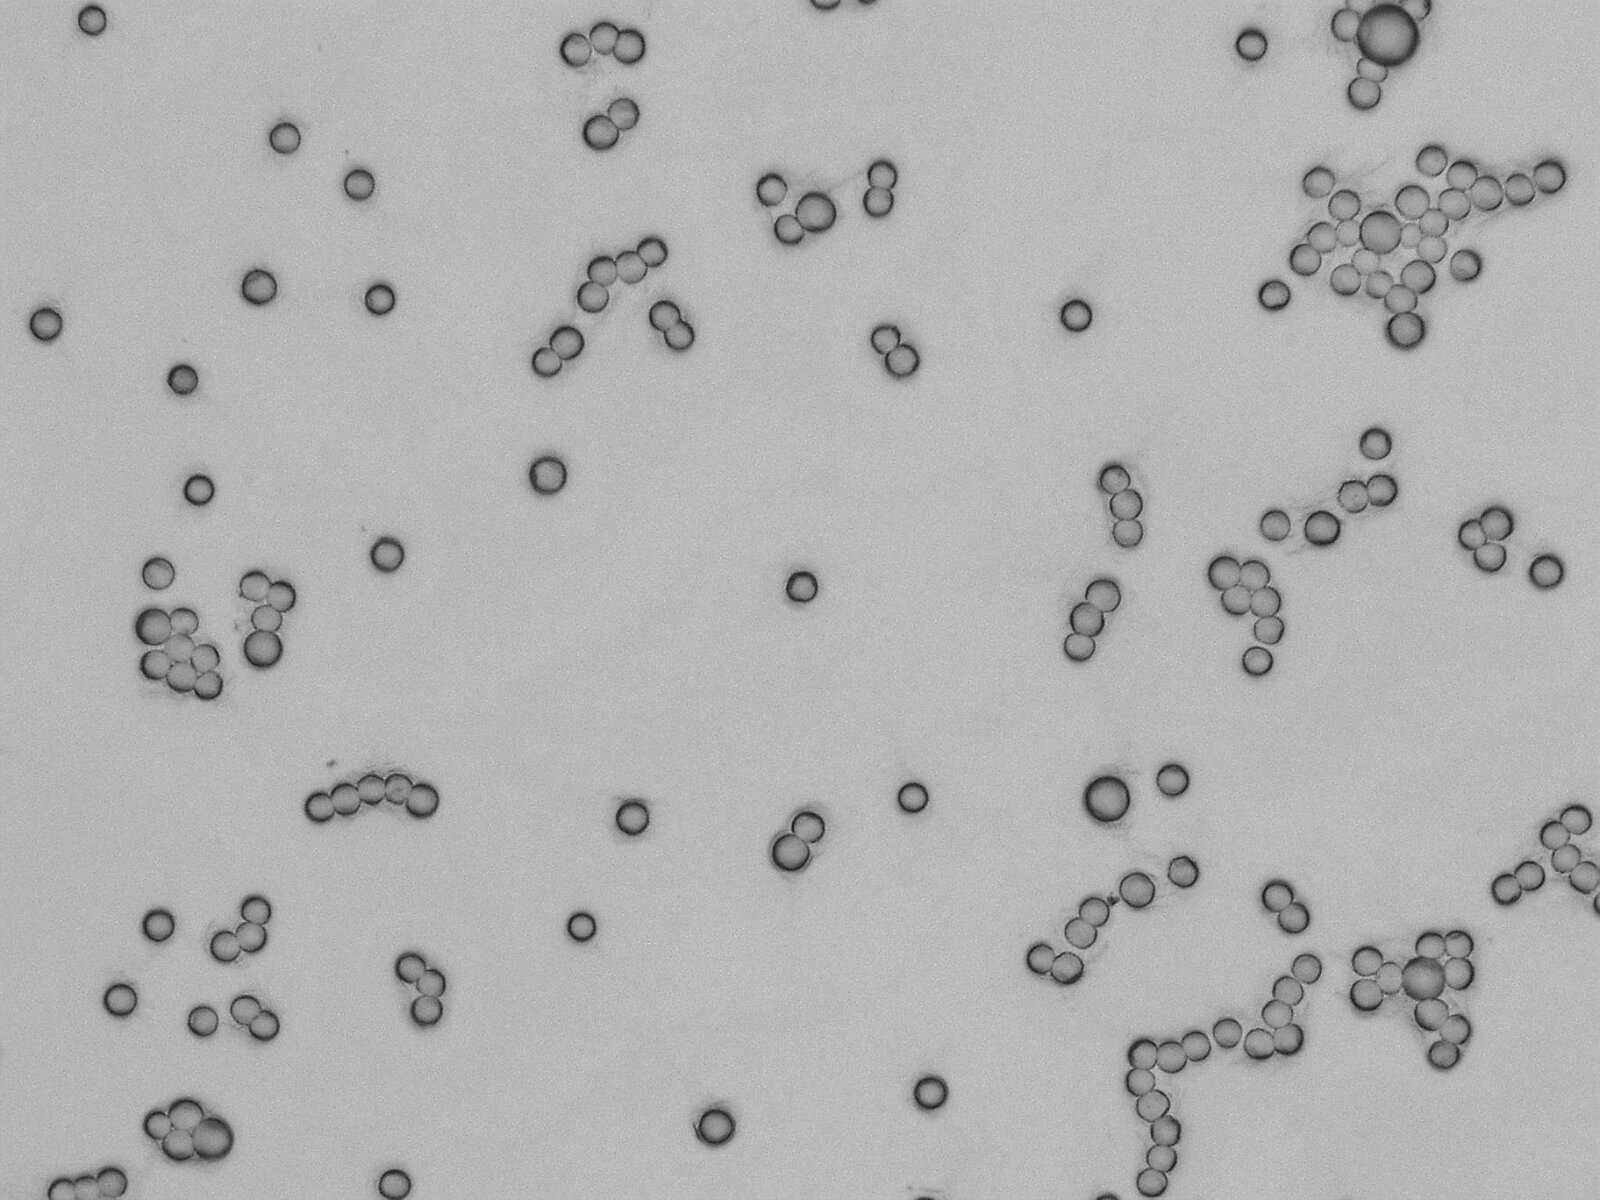
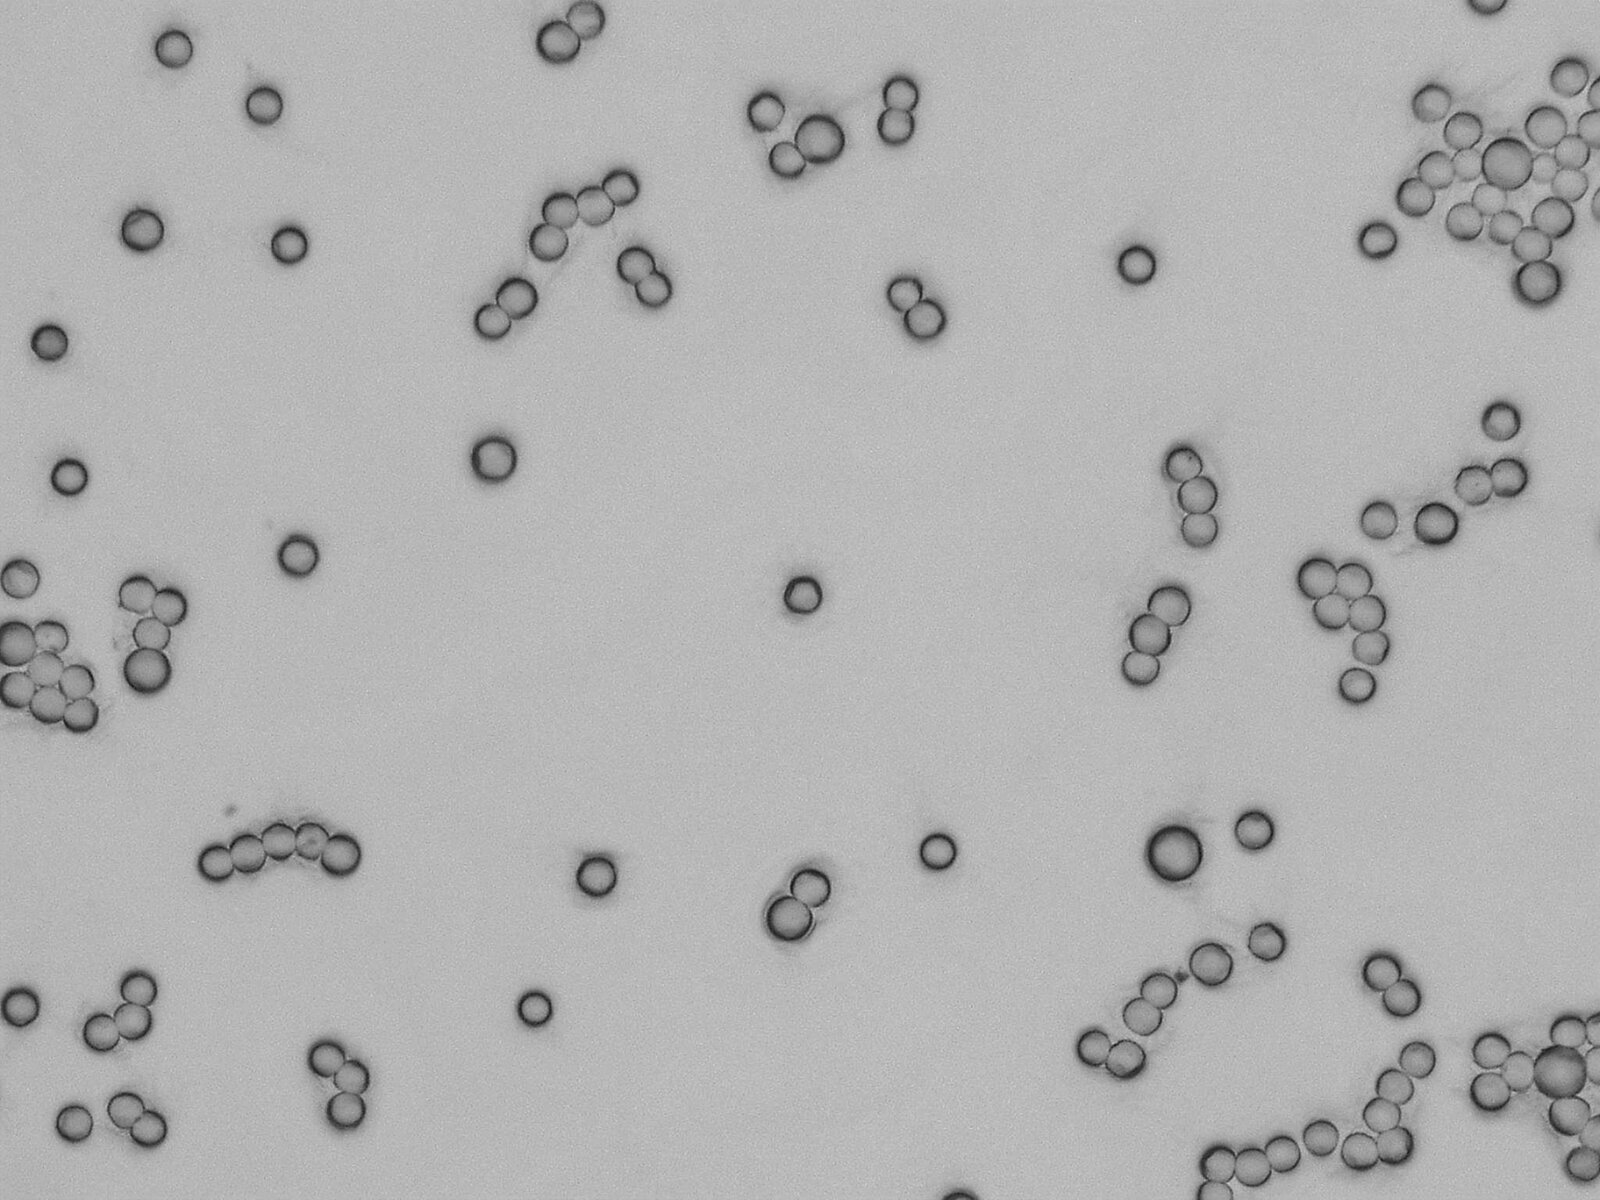
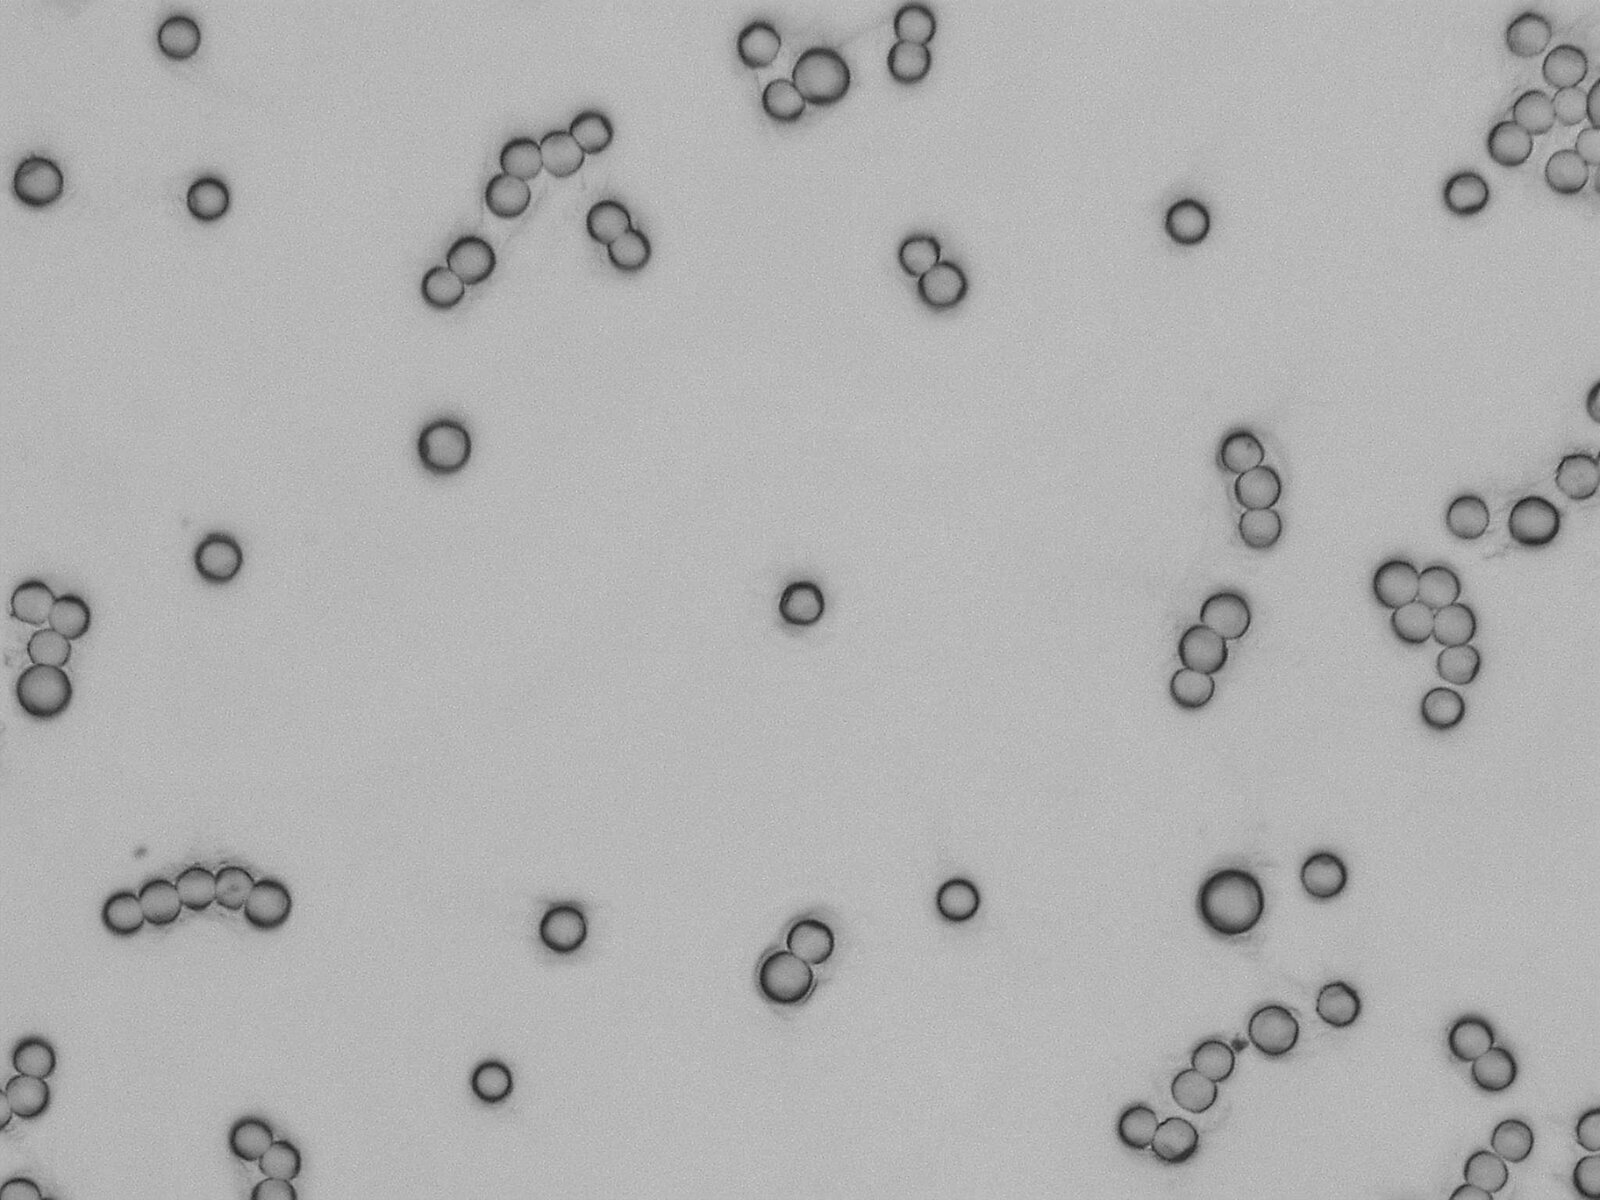

Magnetic Particle Mover
Control particle motion. Accelerate progress.

Magnetic Particle Mover – permanent magnetic tool for contactless guiding of magnetic particles. Group manipulation. Selective separation — with stable real-time performance.
Still facing challenges with precise control at the micro- and nanoscale due to contact?
We understand how frustrating these limitations can be — from damaged samples to imprecise targeting and unreliable processes. That’s why we’re working on contactless magnetic control of ferromagnetic nanoparticles to overcome these barriers.
Here are some of the key problems we’ve identified:
- Medications do not reach their target location accurately.
- Simultaneous control of many particles is mechanically hardly feasible.
- Miniaturized devices require actuators, yet there is no space for motors.
- Sensitive samples are damaged by mechanical manipulation.
- Intervening mechanically inside the body or in very small vessels/tissues is not possible.
Our Solution

Permanent magnetic tool
Magnetic Particle Mover
This is a system for guiding the motion of ferromagnetic nanoparticles. Applications include macroscopic particles and nanoparticle-doped cells, magnetic drug targeting, and more. You can program particle movements with supplied software and observe them under digital microscopes.

How it works
From magnetic fields and field gradients to precise motion
The system generates a magnetic field and superimposed field gradients. These field gradients are tunable in amplitude and direction. This allows for the controlled motion of magnetized particles.

What You Gain
Precise Control of particle motion in two or even in three dimensions
- High-precision control of magnetic fields in two dimensions
- Real-time control with supplied software
- Easy operation, steered by stepper motors
- Low construction height - Ideal for laboratory tables or in vitro experiments

Where It Helps
Key Application Areas
- Cell biology: Contactless manipulation of individual cells for tissue engineering and stem cell research.
- Magnetic separation: Separation of cells, pathogens, or biomolecules using magnetically labeled nanoparticles on a chip.
- Microrobotics: Control of therapeutic microrobots for minimally invasive applications.
- Microassembly: Precise positioning and assembly of tiny magnetic components.
- Lab-on-chip development: Integration of magnetic actuators for complex microfluidic systems.
Two lenses provide flexibility
See the difference: compare 10 µm particles across lenses and zoom levels.

Ready to move beyond contact-based control?
Talk to our team and discover what contactless magnetic control can do for your application.
Dr. Stefan Hiebel
+49 6002 9379-46
shiebel(at)sekels.de